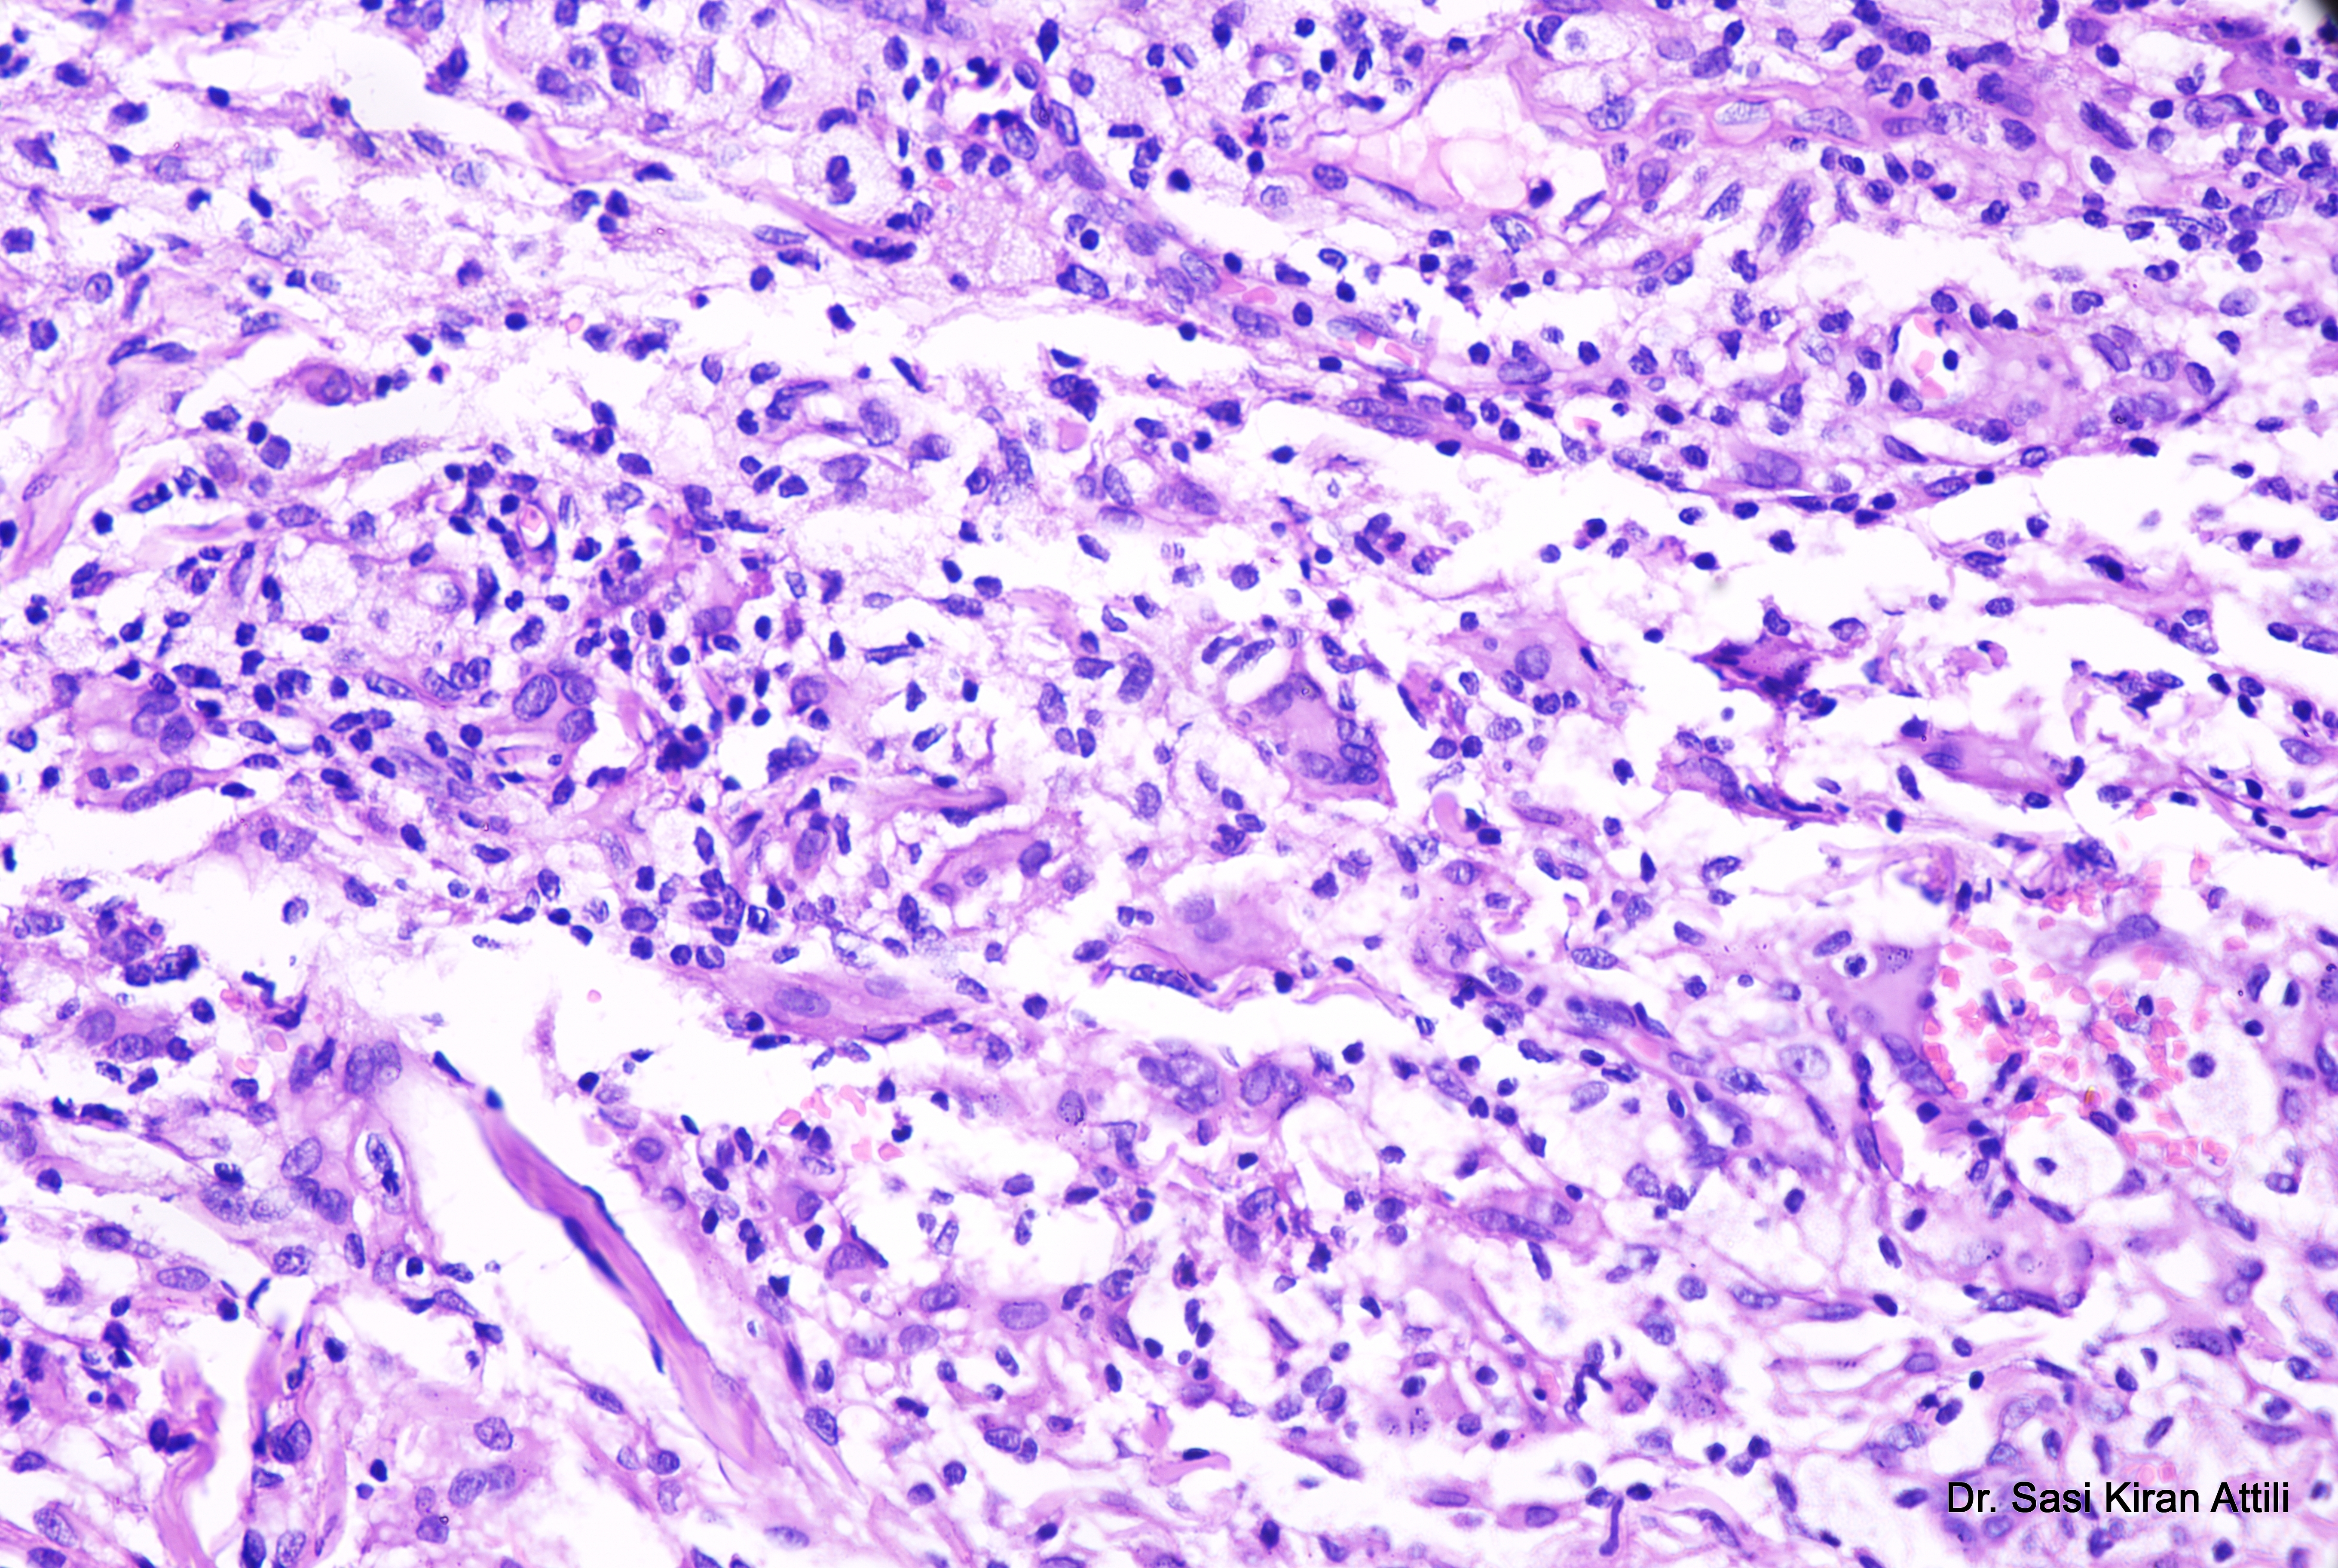

Case Number : CASE 4613 - 29 March 2025 Posted By: Admin_Dermpath
Please read the clinical history and view the images by clicking on them before you proffer your diagnosis.
Submitted Date :
A 21-year-old male presented with a 2-year history of multiple brownish skin lesions over the face, neck, both axillae, both upper limbs, both popliteal fossae, and both flanks, with aggregation on the flanks over the last 4 months. Examination revealed multiple confluent necrotic macules and papules over the face, auricular area, axillae, inguinal regions, knees, and flanks, with ill-defined yellowish macules on the upper and lower lips and buccal mucosae. Genital mucosa was normal. Cerebral

Join the conversation
You can post now and register later. If you have an account, sign in now to post with your account.